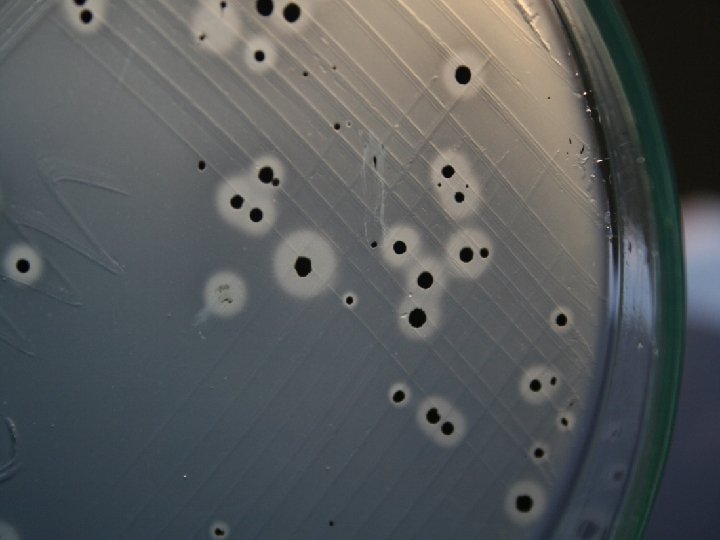
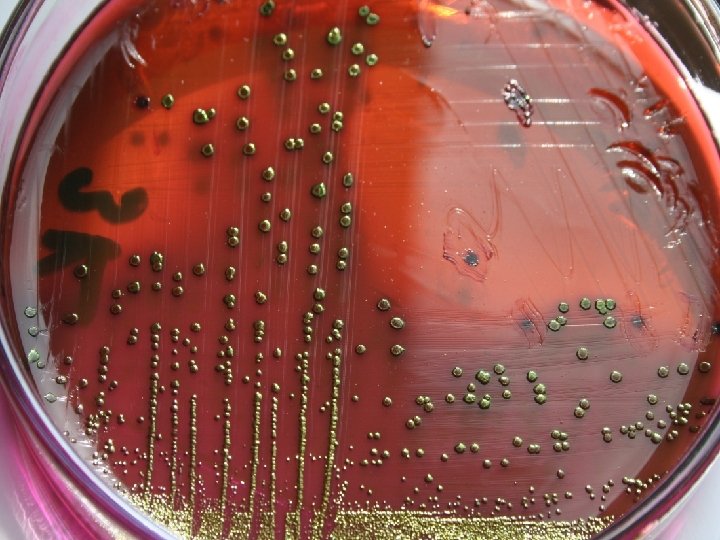

ET ENDSTRSNDE HJYEN Yrd Do Dr Fulya TAI










































- Slides: 42

ET ENDÜSTRİSİNDE HİJYEN Yrd. Doç. Dr. Fulya TAŞÇI Mehmet Akif Ersoy Üniversitesi Veteriner Fakültesi Besin Hijyeni ve Teknolojisi Anabilim Dalı

ØSağlıklı yaşam için gıdaların güvenli bir şekilde hazırlanması gerekir. üHastalıklar üZehirlenmeler üİş gücü kaybı üMüşteri kaybı önlenir.

Hijyen nedir? ØSağlığa zarar verecek ortamlardan korunmak için yapılacak uygulamalar ve alınan temizlik önlemlerinin tümü hijyen olarak tanımlanır.

ET Ø Türk Gıda Kodeksi Et Ürünleri Tebliğine Göre Et; Sığır, manda, koyun, keçi gibi büyük ve küçükbaş hayvanlar; tavuk, hindi, kaz, ördek, beç tavuğu gibi evcil kanatlı hayvanlar ile tavşan ve domuzdan elde edilen, insan tüketimine uygun olan tüm parçalarına denir. Ø Yeterli olgunluğa erişmiş, sağlıklı hayvanlardan (büyük-küçük baş, kanatlı ve su hayvanları) tekniğine uygun şekilde edilen yenilebilir hayvansal dokulara et denir.

ETİN ÖNEMİ § Hayvansal proteinler (jelatin hariç) esansiyel aminoasitleri yeterli ve dengeli oranda içermektedirler. § Kalsiyum dışında diğer mineraller özellikle fosfor ve demir bakımından iyi bir kaynaktır. § Yağlı etler A, D, E, K; § Normal veya yağsız etler B grubu vitaminler yönünden zengindir. § Ette % 0. 5 -1. 5 arasında karbonhidrat bulunur. § Bunun büyük bir kısmını (% 0. 8 -1) glikojen oluşturur § Et, hayvansal gıdalar içersinde vitaminler, bazı minareller ve üstün kaliteli proteinler yönünden zengin, iştah arttırıcı, lezzetli, doyurucu ve üretimi kolay bir besindir.

MİKROORGANİZMA üMikroorganizmalar gözle görülmeyen küçük canlılardır. üHastalıklara üZehirlenmelere üEtte bozulmalara neden olurlar.

MİKROORGANİZMALAR GIDAYA NASIL BULAŞIR? Gıdaların mikroorganizmalar ile bulaşma kaynakları ü İnsanlar ü Hava ü Çiğ gıdalar ü Hayvanlar ü Bitkiler ü Toprak ü Su ü Alet ve ekipmanlar

İNSAN: Ağız ve burun mukozası dışında el, deri ve özellikle apseli yaralar önemli kontaminasyon kaynaklarıdır.


HAYVAN:

EKİPMAN: Hayvansal gıda işleminde kullanılan alet ve ekipmanın, uygun temizlik ve dezenfeksiyonun yapılmaması

PERSONEL HİJYENİ v Et ve et ürünleri ile temasta bulunan personel Kolay temizlenebilir, açık renkli, temiz ü Çalışma kıyafetleri (önlük vb. ), ü Koruyucu kıyafetler, ü Başlık, ü Çizme veya özel ayakkabı, ü Eldiven giymelidirler. ü Temiz ve kirli bölümde çalışanların kıyafetlerinin rengi farklı olmalıdır.

üETİ, KENDİMİZDEN KORUMAK İÇİN ÖZEL KIYAFET GİYMEK ZORUNDAYIZ




PERSONEL HİJYENİ-SAĞLIK DURUMU v Sarılık v İshal v Kusma v Ateşle birlikte boğaz ağrısı v Gözle görülebilir infekte olmuş deri lezyonları (yanıklar, kesikler vb. ) v Göz, kulak veya burun akıntısı Yukarıda belirtilen tipte sağlık sorunları olan personel hastalığını mutlaka yönetime bildirmelidir. NEDEN?

PERSONEL HİJYENİ-SAĞLIK DURUMU v. Et ile temas eden personel kişisel temizliğine özen göstermelidir. ASLA YAPILMAMALIDIR !!

v. Personel, etin mikroorganizma ile bulaşmasına yol açacak davranışlardan kaçınmalıdır. üSigara içmemeli üTükürmemeli üSakız çiğnememeli üÇalışma alanında yemek yememeli üEt üzerine hapşurmamalı ve öksürmemeli ASLA YAPILMAMALIDIR!!!!!

v. Personel aşağıdaki durumlarda mutlaka ellerini yıkamalıdır. üGıda ile temas etmeden önce üTuvalet kullanımından hemen sonra üÇiğ gıdalara yada kontamine olmuş maddelere temas ettikten sonra üKimyasal madde kullandıktan sonra üSaçlarınızı elledikten veya taradıktan sonra üSigara içtikten sonra üPara alışverişinden sonra üBurnunuzu temizledikten sonra üHayvanları elledikten sonra üÇöplere ve bozulmuş gıdalara dokunduktan sonra ELLER MUTLAKA YIKANMALIDIR

üHastalık yapan mikroorganizmalar kişiden kişiye en çok eller yolu ile bulaşmaktadır. üEl sabunlarının üzerinde bakteri kaldığı için bunun yerine sıvı sabun kullanılmalıdır. üKesik ve yaralar uygun, suya dayanıklı yara bantları ile kapatılmalıdır.

üTırnaklar kısa kesilmelidir üOje sürülmemelidir. üYüzük, saat, bilezik vb. takılar takılmamalıdır. Bunların üstüde ve aralarında mikrop yaşar.

üPersonel, tüketime hazır hale gelmiş gıdalardan temastan kaçınmalıdır.

FARK NEDİR ?

YANLIŞ DOĞRU NEDEN ?

PARÇALAMA VE KEMİKLERİN AYRILMASI SÜRESİNCE HİJYEN v Parçalanacak olan etler ihtiyaç duydukça kademeli olarak parçalama bölümlerine getirilmelidir. v Farklı hayvan türleri etlerinin parçalanması için onay almış tesislerde çapraz bulaşmayı önleyici önlemler alınmalı, gerektiğinde farklı hayvan türlerine ait işlemler ayrı zaman ve yerde yapılmalıdır.

v. Parçalama, kemikten ayırma, temizleme (trimming), dilimleme, ambalajlama ve paketleme sırasında etin iç sıcaklığının +4 0 C veya daha düşük olması sağlanmalıdır.

v. Parçalama, kemikten ayırma, temizleme (trimming), dilimleme, ambalajlama ve paketleme sırasında karaciğer, böbrek vb sakatatların sıcaklığının +3 0 C veya daha düşük olmalıdır.

v Parçalama odasının sıcaklığının +12 0 C yi geçmemesi gerekir.

PARÇALAMA VE KEMİKLERİN AYRILMASI SÜRESİNCE HİJYEN v Parçalama işleminin mezbaha ile aynı yerde bulunan bir tesiste yapılması durumunda et sıcak iken parçalanabilir. Bu durumda etin geciktirilmeden parçalama odasına getirilmesi ve parçalamayı takiben hemen uygun bir soğutma odasına nakledilmesi gerekir. v Et, parçalama tesisine gelir gelmez parçalanmayacaksa, bekleyeceği süreye bağlı olarak soğuk depo veya şok muhafaza deposuna alınmalıdır. v Parçalama işlemi sonucunda ortaya çıkan artıklar kapaklı kaplarda toplanarak en kısa sürede çalışma alanlarından uzaklaştırılır. Parçalanmış et ve sakatat başka bir işlem yapılmayacaksa en kısa sürede soğuk depoya nakledilmelidir.


üAçım ve söküm işlemleri, dolum, temizleme, paketleme, etiketleme, satış işlemleri için çalışma masalarına ihtiyaç vardır. üPaslanmaz materyalden yapılan masaların üst yüzeyi paslanmaz çelik olmalı, üst yüzey tek parça yapılmalıdır.

MAMÜL MADDE ÜRETİMİ vÜrünün teknolojisi başka bir sıcaklık derecesini gerektirmedikçe üretim işlemlerinin yapıldığı odaların sıcaklığı +12 0 C’yi geçemez. v. Muhafaza odalarının dereceleri ürünün özelliğine uygun olarak ayarlanır ve odaların kapasitesinin üzerinde depolama yapılmaz. v. Muhafaza odalarında ürünlerin zemine ve duvarlara temas etmeden depolanmasını sağlayacak bir düzenek bulunur.


üAmbalajlama malzemelerinin hijyenik olması, üorganoleptik özelliklerini bozmaması, üinsan sağlığı için zararlı olan maddeleri bulaştırmaması, üyeterince dayanıklı olması gerekir. üPaketleme materyali temizlenmeye ve dezenfeksiyona uygun değilse veya paslanmaya müsait ise yeniden kullanılmasına izin verilmez. üTaze et, sakatat, hazırlanmış et ve hazırlanmış et karışımları ve mamul maddeler mutlaka koruyucu bir ambalajla sarılır. üAmbalajlananlar paketlenmelidir. üAmbalajlı ürünlerin konulduğu paketler yalnız bir çeşit ürünü içerir. üAmbalajlanmış ve paketlenmiş et, sakatat ve mamul madde ile bunların ambalajlanmamış ve paketlenmemiş olanları ayrı yerlerde depolanır. ü Her hayvan türüne ait taze et, hazırlanmış et ve hazırlanmış et karışımları, sakatatlar ve et ürünleri için ambalajlama ve paketleme ayrı bölümlerde yapılır. üTaze parça et ve sakatat ambalajlandığında, bu işlem parçalamadan hemen sonra ve hijyen kurallarına uyularak yapılmalı ve ambalajlamadan sonra hemen soğuk depoya alınmalıdır.

üParçalama, kemikten ayırma, ambalajlama ve paketleme işlemlerinin hijyenik olarak ve bir arada yapılabilmesi için aşağıdaki koşulların sağlanması gereklidir: 1) Bu işlemlerin bir arada ve hijyenik olarak yapılmasına imkan verecek genişlikte bir oda veya alan, 2) Ambalajlama ve paketleme malzemesinin üretildiği yerde ve üretildikten hemen sonra koruyucu bir örtü ile sarılmış, 3) Buradan, parçalama tesisine hijyenik bir şekilde getirilmiş, parçalama tesisinde taze eti kontamine edebilecek odalarla hava bağlantısı olmayan; hijyenik, tozsuz, haşere ve kemirgen giremeyen bir odada muhafaza edilmiş, 4) Bu odadan en kısa süre içerisinde parçalama odasına hijyenik şartlarda getirilmiş, olmalıdır.


üYüksek riskli gıdalar 50 C’nin altında veya 630 C’nin üstünde tutulmalıdır. üGıdalar için 50 C ile 630 C arası en tehlikeli bölgelerdir. üDüşük sıcaklık derecelerine en dayanıklı mikroorganizmalar küflerdir. üKüfler -180 C’ye kadar aktivitelerini devam ettirebilmektedirler. üMayalar -120 C’nin altında gelişme gösteremezken, üBakteriler -100 C’nin altında gelişme gösteremezler.

Alet ve Ekipmanların Hijyeni Ön yıkama (40 -60ºC) ↓ Deterjanlı sıcak su ile yıkama (60 -70ºC) ↓ Normal temiz su ile yıkama ↓ Dezenfektanlı çözeltiler ile yıkama ↓ Temiz ve soğuk su ile durulama